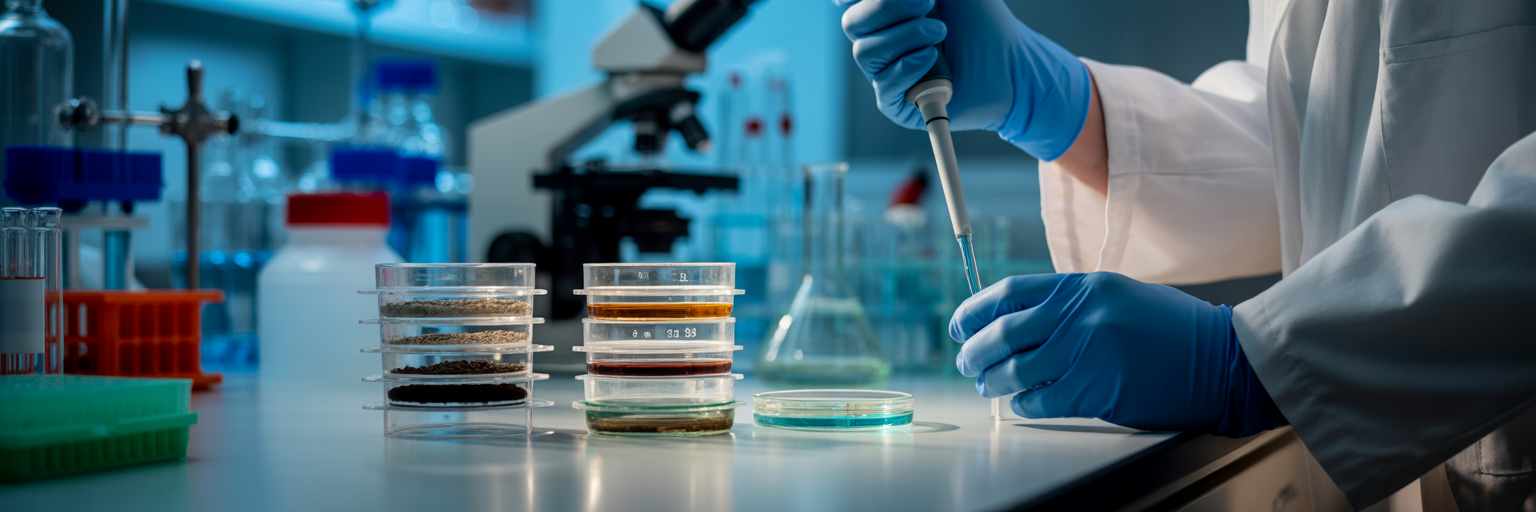
Scientist working with microbial samples in lab.

The Foundation of Microbial Plastic Digestion
The idea of nature consuming plastic sounds like science fiction, but the principle is surprisingly simple. It all comes down to chemistry. Think of a plastic polymer as a long, tightly linked chain. To break it, you need a specific tool. Certain bacteria and fungi have evolved to produce specialized enzymes that break down plastic. These enzymes function like a molecular key designed to fit a specific lock, targeting the chemical bonds that hold the polymer chain together.
These biological scissors snip the long chains into smaller pieces, which the microbes can then absorb and use as food. This process is essentially a form of digestion. The microbes are not just dissolving the plastic; they are consuming its carbon to grow and reproduce, turning synthetic waste into natural biomass. However, not all plastics are on the menu. The most promising candidates are plastics with bonds that enzymes can easily attack, like PET, which is common in water bottles. Its ester bonds are vulnerable. Polyurethane, found in foams and spandex, is also susceptible.
In contrast, plastics like polyethylene (PE) and polypropylene (PP), used in everything from shopping bags to car parts, are far more stubborn. Their simple, strong carbon-carbon backbone is like a chain with no obvious weak points for existing enzymes to latch onto. This chemical resilience makes them incredibly difficult for microbes to digest naturally.
| Plastic Type | Common Uses | Susceptibility to Known Enzymes | Reason for Susceptibility/Resistance |
|---|---|---|---|
| PET (Polyethylene Terephthalate) | Water bottles, food jars, polyester fabric | High | Ester bonds are vulnerable to hydrolysis by enzymes like PETase. |
| Polyurethane (PU) | Foam insulation, spandex, adhesives | Moderate to High | Urethane linkages can be targeted by specific microbial enzymes. |
| Polyethylene (PE) | Plastic bags, milk jugs, packaging film | Very Low | Strong, non-polar carbon-carbon backbone lacks functional groups for enzymes to attack. |
| Polypropylene (PP) | Car parts, food containers, carpets | Very Low | Similar to PE, its stable C-C backbone is highly resistant to enzymatic breakdown. |
This table provides a simplified overview based on current research. Susceptibility can vary based on the specific microbial strain and environmental conditions.
Where Scientists Find These Specialized Microbes
With the basic mechanism understood, the next question is: where do these remarkable organisms come from? Scientists engage in what is called “environmental prospecting,” searching for microbes in the very places we have polluted. The logic is straightforward. Decades of plastic accumulation in landfills, industrial sites, and ocean gyres have created an intense evolutionary pressure cooker. In these environments, any microbe that develops a taste for plastic gains a unique food source and a competitive edge.
As reported by Science.org, marine biologists are actively isolating bacteria from the thin layer of slime that coats plastic debris in the ocean, hoping to find the most effective strains. These polluted ecosystems are a treasure trove of biological innovation. Even more surprising are the discoveries in extreme environments like deep-sea vents and volcanic hot springs, where life has adapted in ways we are only beginning to understand. This incredible adaptability is a recurring theme in nature, reminding us of other survival marvels like the frog that freezes solid and thaws back to life.
Once a promising soil or water sample is collected, the real work begins. In labs across the U.S. and the world, scientists painstakingly isolate individual microbial strains. They cultivate these tiny organisms, sequence their DNA, and identify the specific enzymes responsible for microbial plastic degradation. Each discovery adds another piece to the puzzle of harnessing nature’s recycling power.
The Major Hurdles in Scaling Up
Finding microbes that eat plastic is one thing; turning that discovery into a global solution is another challenge entirely. Before we can deploy armies of plastic-eaters, we have to confront a few significant obstacles. These hurdles explain why figuring out how to break down plastic waste on an industrial scale is far more complex than it sounds.
The path from a lab petri dish to a municipal waste facility is blocked by several practical problems:
- The Speed Problem: In nature, this process is incredibly slow. A microbe might take months or years to degrade a small piece of plastic. For a technology to be viable, it must keep pace with the millions of tons of plastic waste we generate daily.
- Environmental Sensitivity: The most effective enzymes often operate under very specific conditions. They need the right temperature, pH, and oxygen levels to function optimally. Maintaining these “Goldilocks” conditions in massive industrial bioreactors is technically difficult and expensive.
- The Additive Issue: Commercial plastics are rarely pure. They are mixed with dyes, flame retardants, and stabilizers. These chemicals can be toxic to the microbes or physically block the enzymes from accessing the polymer chains they are meant to break.
- The Specialization Limitation: Most of these microbes are picky eaters, specializing in just one type of plastic. Our recycling bins, however, contain a messy mix of different polymers. This means any biological treatment would require a costly and complicated pre-sorting process.
The complexity of these challenges mirrors other intricate biological systems, such as the parasite that turns snails into zombies, where multiple factors must align perfectly for the process to work.
Engineering Better Plastic-Eating Solutions
Faced with the limitations of naturally occurring microbes, scientists are now taking a more hands-on approach. Instead of just finding plastic-eaters, they are actively designing better ones. This field is rapidly advancing, with researchers developing innovative biorecycling plastic solutions to overcome the hurdles of speed, sensitivity, and specialization.
Genetic Engineering for Enhanced Performance
Using powerful tools like CRISPR, scientists can edit the DNA of microbes to create “super-powered” versions. These engineered organisms can be programmed to produce enzymes that are more efficient or more resilient. In a parallel approach known as enzyme engineering, the focus is on modifying the enzyme’s structure itself. By tweaking its amino acid sequence, researchers can design enzymes that work faster, withstand higher temperatures, or tolerate a wider range of pH levels, making them better suited for industrial conditions.
Creating Microbial Consortia
Some challenges are too big for one microbe to handle alone. That is why scientists are assembling “microbial consortia,” or teams of different microbes that work together. In this teamwork approach, one species might perform the initial breakdown of the plastic, while another consumes a toxic byproduct that would otherwise inhibit the process. This division of labor makes the entire system more robust and efficient.
Developing Cell-Free Systems
Another advanced strategy involves removing the microbes from the equation altogether. In cell-free systems, the plastic-eating enzymes are produced in a lab and then extracted. These purified enzymes are then used directly to break down the plastic. This method avoids the complexities of keeping a microbial population alive and healthy, offering greater control and predictability in an industrial setting. These engineering efforts showcase human ingenuity, and you can explore more fascinating stories from the natural world on our main blog.
From Waste Management to Value Creation
The most exciting developments in this field are shifting the conversation from simply getting rid of plastic to transforming it into something valuable. This concept, known as “upcycling,” uses engineered microbes not just to degrade plastic but to convert its fundamental chemical building blocks into high-value new materials. Instead of ending up in a landfill, the carbon from an old water bottle could become a resource.
Imagine microbes converting PET waste into biodegradable bioplastics like PHAs, which could be used for medical implants or compostable packaging. Other pathways could turn plastic into fuels or specialty chemicals used in manufacturing. This approach is a cornerstone of a true circular economy, where plastic is no longer a single-use product derived from fossil fuels but a renewable feedstock. This not only reduces our reliance on oil but also prevents the CO2 emissions that would have been released by incinerating that plastic.
As of plastic eating microbes 2026, this vision is already taking shape. Several U.S.-based startups and research institutions are running small-scale pilot projects to prove the economic and technical feasibility of these upcycling pathways. They are turning a pollution problem into a production opportunity, much like nature’s own incredible transformations, such as how one tiny jellyfish learned to reverse its own aging.
The Practical Path to a Cleaner Future
While the science is promising, it is important to maintain a realistic perspective. The journey from a pilot project to global implementation requires careful planning and oversight. For instance, the release of genetically engineered microbes into the environment for waste treatment would need strict regulatory supervision from agencies like the EPA to prevent unintended ecological consequences.
Then there is the economic reality. For microbial recycling to be widely adopted, it must become cost-competitive with current disposal methods like landfilling and traditional mechanical recycling. This will require further innovation to boost the speed of degradation and lower the energy costs of running large bioreactors. Most importantly, we must recognize that this technology is not a silver bullet. It is a powerful tool that will work alongside, not replace, essential strategies like reducing our overall plastic consumption and improving existing recycling infrastructure.
Widespread industrial use is still likely years away. However, the rapid pace of research suggests that specialized applications, such as cleaning specific industrial waste streams or tackling hard-to-recycle materials, could become a reality by the end of the decade. Nature continues to offer amazing solutions, and we invite you to continue exploring them with us at Nature is Crazy.